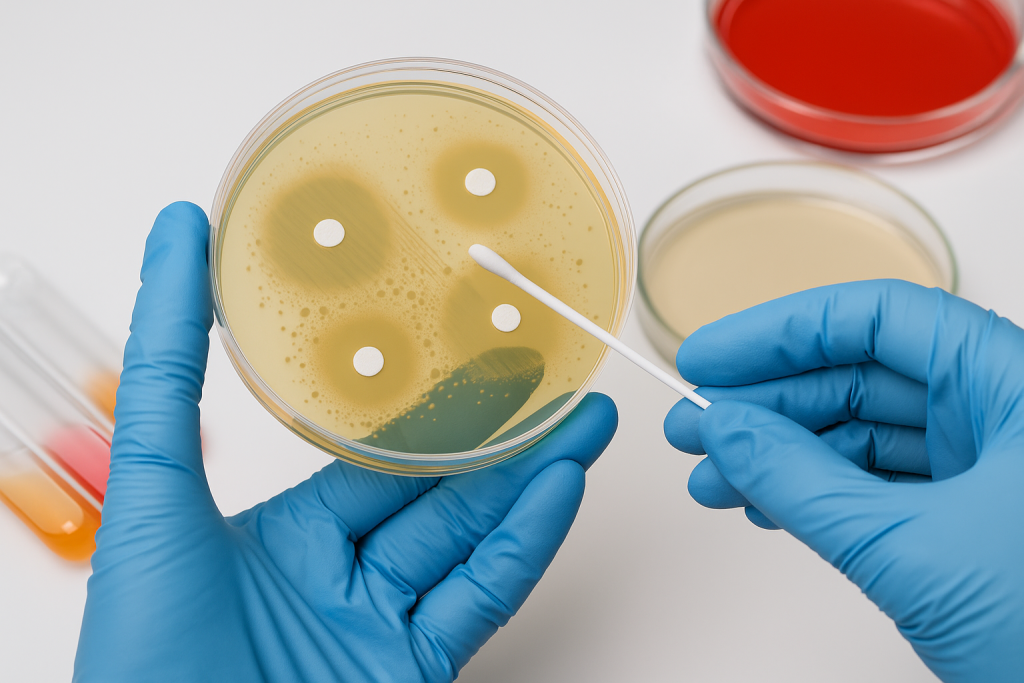
чувствит к антибиот.png

Заявка принята
Что такое уреаплазмоз
Уреаплазмоз — это инфекционное заболевание, вызываемое бактериями рода Ureaplasma, передающееся преимущественно половым путем. Микроорганизм поражает слизистые оболочки мочеполовой системы и может существовать в организме длительное время без выраженных симптомов. При снижении иммунитета или на фоне других инфекций уреаплазма активизируется, вызывая воспалительные процессы. Болезнь требует своевременного выявления и комплексного лечения, чтобы предотвратить осложнения.
Для диагностики уреаплазмоза используют методы лабораторных исследований, которые позволяют точно определить наличие возбудителя.
- ПЦР-анализ мочи, мазков или секрета простаты;
- бактериологический посев с определением чувствительности к антибиотикам;
- анализ крови на антитела к уреаплазме.
Иногда уреаплазмоз протекает бессимптомно, что делает регулярные профилактические осмотры крайне важными. Особенно это касается людей с активной половой жизнью или часто меняющих партнеров. Ранняя диагностика позволяет предотвратить распространение инфекции и снизить риск осложнений.
Основные симптомы уреаплазмоза
Заболевание может проявляться по-разному в зависимости от пола и общего состояния организма. У мужчин чаще отмечаются выделения из уретры, жжение при мочеиспускании и дискомфорт внизу живота. У женщин — обильные выделения, боли внизу живота, неприятные ощущения при половом акте. Иногда симптомы слабо выражены, что затрудняет своевременное обращение к врачу.
Кроме общих проявлений, могут возникать:
- частые позывы к мочеиспусканию;
- неприятный запах выделений;
- ощущение тяжести внизу живота;
- зуд и раздражение слизистой.
При первых подозрениях на инфекцию важно не заниматься самолечением. Только лабораторные анализы могут подтвердить наличие уреаплазмы и определить ее активность. Обращение к врачу помогает избежать ошибок и сократить срок терапии.

Причины развития заболевания
Главной причиной уреаплазмоза является незащищенный половой контакт с инфицированным партнером. Бактерия легко передается при интимной близости и может длительное время находиться в организме без проявлений. Также возможна передача инфекции от матери к ребенку во время родов.
К дополнительным факторам риска относятся:
- снижение иммунитета;
- стресс и хроническая усталость;
- гормональные нарушения;
- наличие других половых инфекций.
Иногда уреаплазмоз может развиться даже у тех, кто уже проходил лечение. Это связано с повторным заражением или неполным курсом терапии. Поэтому важно соблюдать рекомендации врача до конца и проводить контрольные анализы.
Диагностика уреаплазмоза
Диагностика начинается с осмотра врача и сбора анамнеза, после чего назначаются лабораторные исследования. ПЦР-анализ позволяет выявить ДНК возбудителя даже при минимальном его количестве в организме. Это наиболее точный и быстрый способ диагностики.
Для уточнения диагноза часто назначают:
- бактериологический посев для определения чувствительности к антибиотикам;
- общий анализ мочи и крови;
- ультразвуковое исследование органов малого таза.
После получения результатов врач формирует индивидуальный план лечения. Он может включать не только медикаменты, но и иммунокорректирующие средства.
Медикаментозное лечение уреаплазмоза
Основой лечения является антибактериальная терапия, направленная на уничтожение возбудителя. Врач подбирает препараты индивидуально, исходя из результатов посева и чувствительности бактерий. Обычно применяются антибиотики из групп макролидов, тетрациклинов или фторхинолонов.
Во время лечения важно:
- строго соблюдать режим приема препаратов;
- исключить алкоголь;
- воздерживаться от интимных контактов;
- принимать пробиотики для восстановления микрофлоры.
Курс лечения длится от 7 до 14 дней, в зависимости от тяжести заболевания. После его завершения назначаются контрольные анализы для подтверждения излечения.
Восстановление после лечения
После уничтожения возбудителя необходимо восстановить баланс микрофлоры и укрепить иммунитет. Для этого назначаются витаминные комплексы, пробиотики и средства для нормализации обмена веществ. Также врач может рекомендовать физиопроцедуры.
Этап восстановления включает:
- нормализацию питания;
- отказ от вредных привычек;
- соблюдение гигиены;
- укрепление защитных сил организма.
Важно не прекращать терапию преждевременно, даже если симптомы исчезли. Только после контрольных анализов можно говорить о полном выздоровлении.

Профилактика уреаплазмоза
Профилактика заболевания основана на ответственном отношении к своему здоровью и половой жизни. Использование барьерных методов контрацепции значительно снижает риск заражения. Также важно регулярно проходить обследования у врача.
К основным мерам профилактики относятся:
- соблюдение личной гигиены;
- избегание случайных половых связей;
- своевременное лечение инфекций;
- укрепление иммунитета.
Кроме того, при планировании беременности обоим партнерам рекомендуется сдать анализы на половые инфекции. Это снижает риск передачи инфекции ребенку.
Особенности лечения у женщин
У женщин уреаплазмоз может вызывать воспаление шейки матки, влагалища и мочевого пузыря. Поэтому терапия должна быть направлена не только на устранение инфекции, но и на восстановление слизистых оболочек. Врач подбирает препараты, подходящие с учетом гормонального фона и состояния микрофлоры.
Женщинам часто назначаются:
- местные антисептики и свечи;
- препараты для нормализации влагалищной микрофлоры;
- витамины и иммуномодуляторы.
Во время лечения важно исключить переохлаждения и поддерживать гигиену интимной зоны.

Особенности лечения у мужчин
У мужчин уреаплазмоз часто вызывает воспаление уретры и простаты. В результате появляются боли при мочеиспускании, снижение потенции и дискомфорт в паховой области. Без лечения инфекция может привести к бесплодию.
Терапия включает:
- антибактериальные препараты;
- средства для улучшения микроциркуляции;
- физиопроцедуры для восстановления функции простаты.
Лечение проводится под контролем врача с обязательным повторным анализом. Только так можно убедиться в полном излечении.
Осложнения при отсутствии лечения
Без своевременного лечения уреаплазмоз может привести к серьезным последствиям. У женщин — это воспаление матки и труб, выкидыши, бесплодие. У мужчин — простатит, эпидидимит, снижение подвижности сперматозоидов.
Наиболее частые осложнения:
- хронические воспаления органов малого таза;
- нарушения репродуктивной функции;
- снижение иммунитета;
- риск заражения других инфекциями.
Даже при легком течении болезнь может перейти в хроническую форму.
Контроль эффективности терапии
После завершения лечения необходимо убедиться в полном уничтожении возбудителя. Контрольные анализы назначаются через 3–4 недели после окончания курса. Это обязательный этап, который позволяет исключить риск рецидива.
Контроль включает:
- повторный ПЦР-анализ;
- бакпосев;
- оценку состояния слизистых.
Важно не пропустить этот этап, так как даже единичные бактерии могут снова вызвать воспаление.

План лечения в клинике «Жизнь-Опора»
Каждому пациенту подбирается индивидуальная схема терапии. Врач учитывает результаты анализов, наличие сопутствующих заболеваний и общее состояние организма. Такой подход гарантирует эффективность и безопасность лечения.
План лечения включает:
- диагностику;
- антибактериальную терапию;
- восстановительные процедуры;
- профилактические рекомендации.
Врачи клиники придерживаются международных стандартов лечения инфекций мочеполовой системы.
Почему выбирают клинику «Жизнь-Опора»
Пациенты обращаются в клинику «Жизнь-Опора», потому что здесь объединены опыт, современное оборудование и индивидуальный подход. Лечение проводится по международным протоколам, что обеспечивает высокий процент выздоровления.
В клинике работают специалисты с большим опытом в урологии и гинекологии. Они учитывают все особенности организма пациента и подбирают оптимальные схемы терапии.
Пациенты отмечают комфортные условия, внимательный персонал и возможность пройти все процедуры в одном месте.
Клиника «Жизнь-Опора» — это выбор тех, кто ценит качество, безопасность и результат.
Почему выбирают нас?
Вопрос-ответ
Статьи
Отзывы
Персональные предложения для вас
Услуги нашей клиники
Заявка принята
Адрес клиники
Сб – Вс с 9:00 до 19:00
Сб – Вс с 9:00 до 19:00

